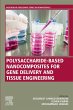
Polysaccharide-Based Nanocomposites for... - Bild 1

Polysaccharide-Based Nanocomposites for Gene Delivery and Tissue Engineering (eBook, ePUB)
Versandkostenfrei!
Sofort per Download lieferbar
160,95 €
inkl. MwSt.
Weitere Ausgaben:

PAYBACK Punkte
80 °P sammeln!
Polysaccharide-Based Nanocomposites for Gene Delivery and Tissue Engineering presents quantitative background on new polysaccharide nanocomposites in a clear and logical way, highlighting the most exciting applications in gene delivery and tissue engineering and their progress. The book focuses on the different types of polysaccharide nanocomposites for gene delivery and tissue engineering and covers polysaccharide hydrogels for tissue engineering and polysaccharide magnetic nanocomposites for gene delivery. Chapters cover various nanocomposites presented in twenty-one separate chapters. This ...
Polysaccharide-Based Nanocomposites for Gene Delivery and Tissue Engineering presents quantitative background on new polysaccharide nanocomposites in a clear and logical way, highlighting the most exciting applications in gene delivery and tissue engineering and their progress. The book focuses on the different types of polysaccharide nanocomposites for gene delivery and tissue engineering and covers polysaccharide hydrogels for tissue engineering and polysaccharide magnetic nanocomposites for gene delivery. Chapters cover various nanocomposites presented in twenty-one separate chapters. This book will be of great interest to all those researching the development and applications of polysaccharide-based nanocomposites for modeling. As polysaccharide-based nanocomposites promise cutting-edge applications in gene delivery and tissue engineering, with their development at the forefront of modern medicine, this book is a welcome title on this exciting science. - Presents quantitative background on new polysaccharide nanocomposites for advanced medicine - Focuses on polysaccharide nanocomposites in relation to gene delivery and tissue engineering - Highlights the most exciting, leading-edge applications in gene delivery and tissue engineering - Covers polysaccharide hydrogels for tissue engineering and magnetic nanocomposites for gene delivery - Offers a logical and useful presentation of polysaccharide nanocomposites organized first by application and then by nanocomposite
Dieser Download kann aus rechtlichen Gründen nur mit Rechnungsadresse in A, B, BG, CY, CZ, D, DK, EW, E, FIN, F, GR, HR, H, IRL, I, LT, L, LR, M, NL, PL, P, R, S, SLO, SK ausgeliefert werden.